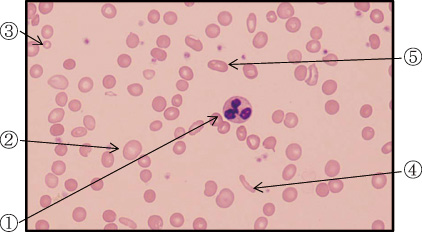

産業医の役割
| 東区・郡元支部 (デイジークリニック) 武元 良整 |
|---|
先日,産業医の講習会に参加しました。「女性労働者の健康管理」がテーマでした。人口減少・女性労働力率上昇の中で,子育て・仕事・家事をこなしながら,女性が社会を支えているとの現状がよく理解でき,非常に有意義でした。その中で女性に多い疾患一覧の解説がありました(表1)。その一部を紹介致します1)。

この表から明らかなように,日常的に「頭痛」を訴える女性は多く,内科外来では,「健診で貧血を指摘され」という方もよく来院されるのではありませんか?表1に示しましたように,1.頭痛,2.子宮内膜症,子宮筋腫,3.甲状腺疾患,6.更年期障害,7.摂食障害は貧血と強い関連性があります。「貧血」と若い女性の「ガン」,この2つは,どちらも訴えが少ないために見逃されやすいのですが,職場健診でこそ「早期発見」できる可能性があります。したがって,産業医は2次検査を指示しなくてはなりません。
「重症貧血」の1例
「健診で貧血を指摘され,2次検査目的で来院した症例」を呈示いたします。
症 例:45歳,女性
主 訴:軽度の息切れ
病 歴:婦人科にて子宮筋腫・貧血を指摘され,3年前に来院。血色素値(Hb:g/dL)は7.2。内科療法ではなく,食餌療法を希望。日常生活では軽度の息切れを認めるのみ。食事にて外来観察中。
背 景:消化器にて消化管精査し貧血の原因となるような所見なし。非喫煙・飲酒せず。
理学所見:身長159.6cm,体重53.5kg,眼瞼結膜は高度貧血,黄疸も軽度あり。息切れ軽度。酸素飽和度100%。
末梢血検査:図1
|
| 図 1 末梢血液像,大小不同2+あり,多染性2+,RBC形態は②~⑤のように多種多様。 ①好中球,②大球性赤血球,③小球性低色素性赤血球,④棒状赤血球,⑤楕円赤血球 (末梢血液画像は鹿児島市医師会臨床検査センター血液検査室へ依頼し撮影いただきました) |
| CBC(complete blood count:全血球計算) |
| RBC:198万/μL,Hb:2.9g/dL,MCV (mean corpuscular volume:平均赤血球容積):56.1f L,MCH(mean corpuscular hemoglobin:平均赤血球血色素値):14.6pg,PLT(血小板数):37.1万/μL |
血液生化学検査:血清鉄:12μg/dL,フェリチン0.7ng/mL(WHO基準では12.0未満は鉄欠乏と診断),ビタミンB12:317pg/mL(基準値180-914),葉酸:10.7ng/mL(基準値4以上)。
臨床経過:表2
表2にCBCの経時変化(3年間)を示します。食餌療法にもかかわらず,貧血は緩徐に進行し,血色素値は7.2から2.9まで低下。自覚症状は軽度の息切れのみで変化なし。

まとめ:鉄欠乏性貧血の治療は「食事をバランスよく」という食事指導が基本です。そして①貧血原因の究明(消化管精査と婦人科への相談),②フェリチン(貯蔵鉄)の治療目標を決め,鉄剤の補充。この2つを念頭においての治療が有用です。
今回の症例は貧血の説明とご本人の納得,栄養士による食餌療法の指導が外来診察時に欠けていたと思います。重症貧血例でしたので,栄養士による食事指導も同時にできたらと今回は痛感しました。
外来での食事指導については友人および県栄養士会の担当者に教えてもらいました。「Hb≦10g/dLの鉄欠乏性貧血」であれば,医科点数表から「貧血食」の指導が可能です。貧血外来で最も多い質問は「食事で気を付ける事は?」という素朴な疑問です。
貧血は急性期疾患ではありません。「痛くもない」「発熱もない」そして「時間の余裕もない」典型的な「鉄欠乏性貧血」の平均年齢43歳(資料未発表)の女性は,受診意欲はあっても,育児・家事・仕事に追われています。貧血治療だけでなく栄養指導まで,その説明責任を外来診療で果たさなければと考えています。
文 献
1. 平成29年度産業保健実践講習会-福岡会場-:女性労働者の健康管理について,P10編集. 公益社団法人福岡県医師会,公益社団法人産業医学振興財団. 2017.5.7発行
(C)Kagoshima City Medical Association 2017